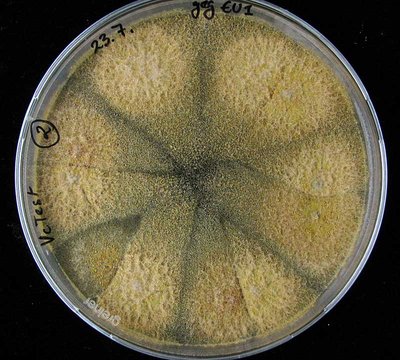

Ein Virusbefall hemmt die Aggressivität des Schadpilzes: Läsionen verheilen, die Rinde bleibt geschlossen und Wasserreiser welken nicht ab. Um diesen Vorgang auf allen Flächen anzustoßen, kann man erkrankte Bäume sogar mit einem Virus-tragenden Pilz beimpfen.
Seit über zwanzig Jahren breitet sich der Esskastanienrindenkrebs in Baden-Württemberg und Rheinland-Pfalz aus. Nach seiner Entdeckung wurde der Erreger Cryphonectria parasitica 1992 zunächst nur in wenigen Waldstücken im Ortenaukreis in Baden-Württemberg und der Südlichen Weinstraße in Rheinland-Pfalz nachgewiesen. Im Rahmen des INTERREG-Projekts "Die Edelkastanie am Oberrhein" konnten wertvolle Erkenntnisse über die weitere Ausbreitung und die genetische Diversifizierung des Schadpilzes gewonnen werden.
Genetische Unterschiede an den Pilzisolaten legen nahe, dass der Erreger inzwischen mehrfach unabhängig nach Süddeutschland eingeschleppt worden ist. Besonderes Augenmerk wurde auf die durch ein Pilzvirus übertragbare Hypovirulenz (verminderte Aggressivität des Schadpilzes) gelegt, die Möglichkeiten zur Eindämmung der Krankheit eröffnet.
Forstliche Nutzbarkeit gefährdet?
Mit der Einschleppung des Rindenkrebserregers Cryphonectria parasitica nach Europa 1938 befürchtete man zunächst, die vorderasiatisch-europäische Esskastanie (Castanea sativa) könnte durch die invasive Krankheit nahezu aussterben – ähnlich wie die amerikanische Esskastanie C. dentata im frühen 20. Jahrhundert. C. dentata war bis damals in den östlichen USA die häufigste Hartholzart und stellte 25 % des Holzvorrates: 3,5 Mrd. Bäume starben durch die Krankheit ab, was in der Forstgeschichte eine unvergleichbare Katastrophe darstellt. Glücklicherweise zeigte sich C. sativa weniger anfällig, sodass weniger das Überleben der Baumart, sondern "nur" deren forstliche Nutzbarkeit in Frage steht. C. sativa überlebt die Krankheit in der Regel, jedoch ist das Stammholz durch teilweises Absterben der Rinde (Abb. 1 und 2) und der Baumkrone (Abb. 3) oft weitgehend entwertet. So wird die Verbreitung des Pilzes in Südwestdeutschland seit 1992 (nicht zuletzt auch wegen der Quarantäneregelungen der EU) durch die FVA und die Biologische Bundesanstalt (heute Julius-Kühn-Institut) sorgfältig verfolgt.

Abb. 1: Typischer Esskastanienrindenkrebs mit orangeroten Sporenlagern, aufreißender Rinde und Wasserreisern, die wieder abwelken.

Abb. 2: Nur noch etwa ein Drittel des Stammumfangs (oben) ist an diesem Querschnitt vital.

Abb. 3: Durch den Rindenkrebs absterbende Kronenteile.
Pilzbiologie
Bei C. parasitica handelt es sich um einen Schlauchpilz (Askomyzet), der in Deutschland in den ersten beiden Jahrzehnten nach der Einschleppung nur die Nebenfruchtform (Endothiella parasitica, Abb. 1 und 4) ausbildete. Deren Konidien entstehen in großen Mengen auf der befallenen Rinde. Insbesondere bei feuchter Witterung treten sie als schleimige Masse aus kleinen, pusteligen orangeroten Fruchtkörpern (Pyknidien) aus und werden mit Regenwasser, jedoch auch von Tieren (beispielsweise Insekten, Abb. 6) und auch durch den Menschen übertragen. Der Neubefall findet über kleine Rindenrisse und vor allem über Rindenverletzungen statt.

Abb. 4: Orangerote Pyknidien (Endothiella-Nebenfruchtform) von C. parasitica auf der Rinde einer befallenen Esskastanie.

Abb. 5: Frische Rindennekrose; unter der abgestorbenen Rinden finden sich kleine cremfarbene Mycelfächer des Schadpilzes.

Abb. 6: Die Befallsstellen (Mycelfächer von C. parasitica rechts im Bild) werden oft von Käferlarven (links im Bild) besiedelt.
Fruchtbäume (Maroni) infizieren sich besonders leicht an der Veredelungsstelle. Der Befall kann mehr als ein Jahr lang latent bleiben ohne auffällige Symptome hervorzurufen, da das Myzel als kleiner Mycelfächer in der Rinde wachsen und überleben kann (Abb. 5, 6). Erreicht der Pilz das Kambium, stirbt dieses fleckweise ab und je nach Zuwachs reißt am Wundrand die Rinde auf. Die Überwallung der Befallsstelle gelingt dem Baum in der Regel nicht (Abb. 3), sondern die Wundränder werden immer wieder neu infiziert, so dass man von einem Rindenkrebs spricht. Bei stammumfassender Ringelung können Krone oder größere Äste insgesamt absterben. An der dicken Borke von älteren Bäumen schreitet die Infektion meist nur langsam voran, auch sind Rindenrisse gegebenenfalls schwerer zu erkennen.
In den ersten Jahrzehnten der Ausbreitung von C. parasitica in Italien entdeckten Forschende, dass manche Rindeninfektionen deutlich milder verlaufen und sogar verheilen können. Bei anschließenden molekulargenetischen Untersuchungen fand man einen sogenannten Hypovirulenzfaktor, der sich als virusähnliche doppelsträngige (ds-)RNA herausstellte; man spricht auch von einem Hypovirus (im Folgenden auch Virus genannt). Die Übertragung des Virus erfolgt nur direkt von Pilz zu Pilz über Hyphenverbindungen, sogenannte Anastomosen. Letztere entstehen nur, wenn die einzelnen Myzelien kompatibel sind, das heißt, der gleichen vegetativen Kompatibilitätsgruppe (vc-Gruppe) angehören. Es gibt viele verschiedene vc-Gruppen (74 und mehr), deren genetische Information bei der Askosporenbildung (Hauptfruchtform) neu kombiniert werden kann, wodurch weitere vc-Gruppen entstehen können. Eine höhere Zahl dieser vc-Gruppen in einem Gebiet erschwert also die Virusübertragung. Solange nur die Nebenfruchtform auftritt (siehe oben), handelt es sich um genetisch unveränderte Klone.
Entwicklung bis 2010
In Waldbeständen der Ortenau wurden in den Jahren nach der Erstentdeckung zunächst nur die vc-Gruppe EU-2, in Rheinland-Pfalz nur EU-65 nachgewiesen. Im Trockenstress des Jahres 2003, unter der auch die Esskastanie zu leiden hatte, kam es offensichtlich zu stärkerer Ausbreitung der Krankheit und bereits latent vorhandene Infektionen traten deutlicher zutage. So wurden bis 2010 aus Waldflächen (auch in den Landkreisen Rastatt und Heidelberg) insgesamt sechs verschiedene vc-Gruppen isoliert, drei weitere aus Einzelvorkommen in Grünanlagen. Von einer Ausnahme abgesehen wurde jeweils nur eine vc-Gruppe pro Bestand gefunden. Dies bedeutet, dass die Krankheit mit hoher Wahrscheinlichkeit mindestens neunmal nach Deutschland eingeschleppt worden sein muss. Der überwiegende Teil der damaligen Pilzpopulationen gehörte der vc-Gruppe EU-2 an. Die ersten Nachweise von C. parasitica im Elsass waren 2002 erfolgt – mit den vc-Gruppen EU-5 in Wangen bei Strasbourg und EU-65 bei Kaysersberg.
Neue Erkenntnisse
Im Zuge des INTERREG-Projekts konnte man Kastanienbestände intensiv untersuchen, wobei Forschende auch neue Befallsflächen entdeckten. Mit 14 vc-Gruppen wurde eine deutlich höhere Vielfalt nachgewiesen. In Abb. 7 ist die Methodik dargestellt. Wenn auch weiterhin auf den meisten Flächen nur eine vc-Gruppe vorhanden ist, gibt es inzwischen einige Flächen, auf denen zwei oder mehrere vc-Gruppen zu finden sind.
Die sexuelle Rekombination wird durch den Kreuzungstyp (+/-) gesteuert, der die vc-Gruppen überlagert. Bei den Untersuchungen fand man beide Kreuzungstypen, womit das Potential für geschlechtliche Fortpflanzung nachgewiesen ist (Abb. 8). Zu diesem Befund passend wurde erstmalig 2012 in Deutschland die Hauptfruchtform des Pilzes gefunden (Abb. 9 und 10). Eine daraus entstandene weitere Diversifizierung des Erregers konnte am Standort Edenkoben in Rheinland-Pfalz nachgewiesen werden. Die Analyse des Kreuzungstyps und weiterer genetischer Merkmale zusätzlich zu den vc-Gruppen zeigt eine größere Diversität des Pilzes an als bisher bekannt. Allerdings ist die Zahl der vc-Gruppen im Vergleich zu anderen europäischen Ländern nach wie vor gering.

Abb. 9: Die erstmalig in Deutschland im Rahmen des INTERREG-Projekts nachgewiesene Hauptfruchtform von C. parasitica: Gruppen von Perithecien mit schlauchförmiger Öffnungen.

Abb. 10: Freigelegtes kugeliges Perithecium der Hauptfruchtform mit schlauchförmiger Öffnung.

Abb. 11: Verheilende Läsion mit hypovirulentem Befall. Die Rinde bleibt geschlossen und Wasserreiser welken nicht ab.
Hypovirulenz
Ein natürlich vorkommender, spezifischer Virusbefall in C. parasitica hemmt die Aggressivität dieses Schadpilzes entscheidend. Bis zum Jahr 2010 konnten in Deutschland unter 400 Isolaten von C. parasitica nur vier hypovirulente Pilzisolate festgestellt werden. Eine wesentliche Neuigkeit im INTERREG-Projekt ist das vermehrt festgestellte Auftreten von heilenden Rindenläsionen in der Ortenau (Abb. 11) und der vermehrte Nachweis von weiteren 35 hypovirulenten Pilzisolaten in der Ortenau und im Landkreis Rastatt mit molekulargenetischen Methoden. Obwohl sie von unterschiedlichen Flächen stammen und auch verschiedenen vc-Gruppen (EU-2, EU-5, EU-13) angehören, zeigen genetische Untersuchungen, dass die Viren alle einheitlich dem deutschen Subtyp des Virus angehören. Auf drei speziell untersuchten Flächen konnten Forschende an 24 % der befallenen Esskastanien das Virus nachweisen.
Diese Ergebnisse zeigen mehrfach die natürliche Übertragung und Ausbreitung der Hypovirulenz, so dass hier ein harmloserer Krankheitsverlauf erwartet werden kann. Um diesen Vorgang auf anderen Flächen anzustoßen oder zu beschleunigen, kann man erkrankte Bäume mit einem Virus-tragenden Pilz der gleichen vc-Gruppe beimpfen. So kann die Hypovirulenz auch in Bestände eingebracht werden, die bisher nur von virulenten Pilzstämmen infiziert waren. Das Verfahren wurde versuchsweise in der Südlichen Weinstraße angewendet, wo man bisher keine natürlich auftretende Hypovirulenz beobachten konnte. Dafür wurde das aus der Ortenau stammende Virus auf einen lokalen Pilzstamm übertragen. Ein Jahr nach der Beimpfung konnten Forschende jetzt die Virusübertragung an lebenden Bäumen durch Reisolierung bestätigen. In den nächsten Jahren muss sich zeigen, ob eine weitere Übertragung der Hypovirulenz auf erkrankte Nachbarbäume erfolgt und ob sich schließlich die Bestände insgesamt gesünder entwickeln werden.
Weitere aktuelle Schadorganismen an der Esskastanie
Tintenkrankheit
Auf manchen Standorten wird ein plötzliches Absterben von Esskastanien beobachtet. Untersuchungen ergaben unter anderem den Nachweis von Phytophthora sp.. Aus mehreren Bodenproben aus der Ortenau wurden Isolate dieser Gattung gewonnen. Die Gattung Phytophthora aus der Gruppe der "pilzähnlichen Organismen" oder "Algenpilzen" enthält Arten, die im Kambialbereich von Gehölzen tödliche Infektionen verursachen können. Die Besonderheit dieser Organismengruppe sind ihre Zoosporen, die im Wasser verbreitet werden können. Entsprechend sind als disponierende Faktoren für den Phytophthora-Befall frische oder staunasse Böden sowie Abflussbereiche von Waldstraßen bedeutsam.
Japanische Esskastanien-Gallwespe
Das Schadinsekt wurde 2002 in Norditalien erstmals in Europa nachgewiesen. D. kuriphilus breitet sich inzwischen rasant im gesamten Europäischen Esskastaniengebiet aus. In Deutschland wurde das Insekt erstmalig im Sommer 2013 zunächst im Raum Mannheim nachgewiesen. Die jetzt vom Pflanzenschutzdienst der Regierungspräsidien in Kraft gesetzten EU-Quarantänebestimmungen untersagen den Handel mit Esskastanienpflanzen in zahlreichen Gemeinden auch im Umkreis von weiteren Befallsgebieten.
Die Japanische Esskastanien-Gallwespe (Dryocosmus kuriphilus) (Abb. 12) legt ihre Eier in den Knospen von Esskastanien ab (Abb. 13). Im Zuge der Larvalentwicklung entstehen Gallen, die die Ausbildung der Blätter und insbesondere den Fruchtansatz schädigen. Ferner wird durch die Gallwespe die Infektion von Zweigen mit Esskastanienrindenkrebs erleichtert.

Abb. 12: Japanische Esskastanien-Gallwespe (Dryocosmus kuriphilus).

Abb. 13: Befallene Esskastanien-Knospe. (Fotos: D. Hölling)